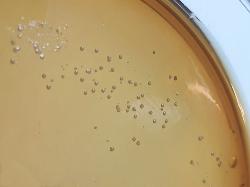

| Lactose- Xylose- and H2S- negative Shigella colonies on XLD agar |
| Genus Shigella |
Taxonomy
Morphology
Cultural characteristics
Biochemical characters
Ecology
Pathogenicity
References
Phylum Pseudomonadota (Proteobacteria), Class Gammaproteobacteria, Order Enterobacterales, Family Enterobacteriaceae,
Genus Shigella, species:
- Shigella boydii Ewing 1949,
- Shigella dysenteriae Castellani and Chalmers 1919 - type species of the genus, old synonym: Bacillus dysentericus Shiga 1897,
- Shigella flexneri Castellani and Chalmers 1919,
- Shigella sonnei (Levine 1920) Weldin 1927.
The Shigella species and Escherichia coli are a single species on the basis of DNA relatedness, but they remain separate species to
avoid confusion.
Genus Shigella, species:
- Shigella boydii Ewing 1949,
- Shigella dysenteriae Castellani and Chalmers 1919 - type species of the genus, old synonym: Bacillus dysentericus Shiga 1897,
- Shigella flexneri Castellani and Chalmers 1919,
- Shigella sonnei (Levine 1920) Weldin 1927.
The Shigella species and Escherichia coli are a single species on the basis of DNA relatedness, but they remain separate species to
avoid confusion.
Gram-negative rods, non-motile, non-encapsulated.
S-type colonies, nonpigmented. Facultatively anaerobic, growth temperature 37 ºC.
Media: Nutrient Agar or Nutrient Broth, Trypticase Soy Agar ± 5% sheep blood, Mac
Conkey Agar.
Media: Nutrient Agar or Nutrient Broth, Trypticase Soy Agar ± 5% sheep blood, Mac
Conkey Agar.
Widely distributed in nature. Isolated from feces, water and soil. The normal habitat is intestinal tract of man and apes.
Shigella species are commonly pathogenic to humans, causing severe gastroenteritis (bacillary dysentery), more severe in children.
S. dysenteriae serotype 1 causes more severe disease than other serotypes and produces an exotoxin (Shiga toxin).
S. dysenteriae serotype 1 causes more severe disease than other serotypes and produces an exotoxin (Shiga toxin).
- J. G. Holt et al., 1994. Facultatively Anaerobic Gram-Negative Rods. Subgroup 1. Family Enterobacteriaceae. In: Begey’s Manual of
Determinative Bacteriology, 9th-edition, Williams & Wilkins, pp 175-189. - Ewing W.H.: Shigella nomenclature. Journal of Bacteriology, 1949, 57, 633-638.
- Castellani A. & Chalmers A.J.: Manual of Tropical Medicine, 3rd ed., Williams Wood and Co., New York, 1919, p. 935.
- Don J. Brenner and J.J. Farmer III, 2001. Family I. Enterobacteriaceae. In: Bergey’s Manual of Systematic Bacteriology, Second
edition, Vol two, part B, George M. Garrity (Editor-in-Chief), pp 587-897. - Adeolu M, Alnajar S, Naushad S, S Gupta R. Genome-based phylogeny and taxonomy of the 'Enterobacteriales': proposal for
Enterobacterales ord. nov. divided into the families Enterobacteriaceae, Erwiniaceae fam. nov., Pectobacteriaceae fam. nov.,
Yersiniaceae fam. nov., Hafniaceae fam. nov., Morganellaceae fam. nov., and Budviciaceae fam. nov. Int J Syst Evol Microbiol
2016; 66:5575-5599.
Positive results for nitrate reduction, methyl red and acid production from D-mannose.
Negative results for H2S production, oxidase, lysine decarboxylase, citrate utilization,
Voges-Proskauer test, urea hydrolysis, phenylalanine deaminase, gelatin hydrolysis,
esculin hydrolysis, DN-ase, lipase, acetate utilization, acid production from lactose,
salicin, adonitol, myo-inositol, sucrose, alpha-methyl-D-glucoside and mucate.
The four species are often reffered to as subgroups A to D. Subgroup A strains are
mannitol non-fermenters (most of them) and the other 3 subgroups are mannitol
fermenters.
- subgroup A: Shigella dysenteriae (15 serotypes)
- subgroup B: Shigella flexneri (14 serotypes)
- subgroup C: Shigella boydii (19 serotypes)
- subgroup D: Shigella sonnei
S. dysenteriae: catalase is not produced by serotype 1, but is usually produced by
strains of other serotypes. Dulcitol is fermented by strains of serotype 5. Indole
production is variable among serotypes.
S. flexneri: dulcitol is fermented by certain biotypes of serotype 6 and 4a some
biotypes may produce gas from sugars.
S. boydii: dulcitol is usually fermented by serotypes 2, 3, 4, 6, and 10. Serotypes 13
and 14 may produce gas from sugars.
Negative results for H2S production, oxidase, lysine decarboxylase, citrate utilization,
Voges-Proskauer test, urea hydrolysis, phenylalanine deaminase, gelatin hydrolysis,
esculin hydrolysis, DN-ase, lipase, acetate utilization, acid production from lactose,
salicin, adonitol, myo-inositol, sucrose, alpha-methyl-D-glucoside and mucate.
The four species are often reffered to as subgroups A to D. Subgroup A strains are
mannitol non-fermenters (most of them) and the other 3 subgroups are mannitol
fermenters.
- subgroup A: Shigella dysenteriae (15 serotypes)
- subgroup B: Shigella flexneri (14 serotypes)
- subgroup C: Shigella boydii (19 serotypes)
- subgroup D: Shigella sonnei
S. dysenteriae: catalase is not produced by serotype 1, but is usually produced by
strains of other serotypes. Dulcitol is fermented by strains of serotype 5. Indole
production is variable among serotypes.
S. flexneri: dulcitol is fermented by certain biotypes of serotype 6 and 4a some
biotypes may produce gas from sugars.
S. boydii: dulcitol is usually fermented by serotypes 2, 3, 4, 6, and 10. Serotypes 13
and 14 may produce gas from sugars.
(c) Costin Stoica

| Antibiogram |
| Encyclopedia |
| Culture media |
| Biochemical tests |
| Stainings |
| Images |
| Movies |
| Articles |
| Identification |
| Software |
| R E G N U M PROKARYOTAE |
|
Legend: + positive 90-100%, - negative 90-100%, [+] positive 75-89%, [-] negative 75-89%, d positive 25-74% of strains
Differential characters of the species: